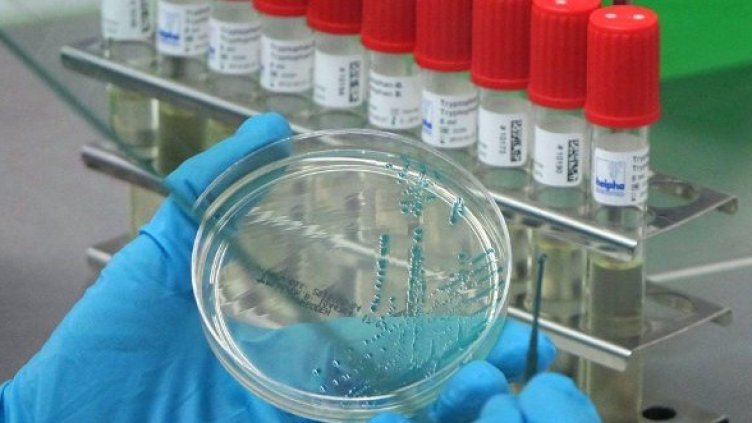
Снимка: БТА

Сериозни опасения за заболял българин от опасната бактерия ешерихия коли плъзнаха из Хасково, след като 66-годишен мъж от хасковско село почина в инфекциозното отделение на местната болница.
От регионалната здравна инспекция са назначили изследвания за евентуалното наличие на опасната бактерия. По вероятно е обаче резултатите да са отрицателни, коментираха епидемиолозите.
Мъжът е постъпил в отделението с остра диария. По показания на лекари мъжът се е върнал наскоро от море.
Медиците са овладели чревната инфекция , но въпреки усилията им пациентът е починал.
Съдебният лекар е установил, че смъртта е настъпила заради остър миокарден инфаркт, каза изпълнителният директор на болницата доктор Тодор Пандов.
Първите микробиологични изследвания са показали наличие на цитробактер. Направени са посявки и за ешерихия коли, резултатите ще бъдат известни до дни, уточниха от болничното заведение.
Всички болници в областта са получили указания за откриване и лечение на опасният щам на ешерихия коли, от който има няколко смъртни случаи в света и повече от 270 заразени.
В България до момента няма потвърден случай на заразен с опасната бактерия, подчерта доктор Светлана Узунова от РЗИ Хасково.

Commerzbank отхвърли оферата за придобиване от UniCredit като твърде ниска
Commerzbank отхвърли оферата за придобиване от UniCredit като твърде ниска  Активите на инвестиционните фондове у нас растат до близо 7,4 млрд. евро в края на март
Активите на инвестиционните фондове у нас растат до близо 7,4 млрд. евро в края на март  Медицинският туризъм - част от икономиката на дълголетието
Медицинският туризъм - част от икономиката на дълголетието  Над 1000 деца и родители превърнаха Day Off: Family Time в празник на семейното време
Над 1000 деца и родители превърнаха Day Off: Family Time в празник на семейното време  Грийн от АЦБ: Не може да сме спокойни, че влиянието на войната в Иран ще бъде временно
Грийн от АЦБ: Не може да сме спокойни, че влиянието на войната в Иран ще бъде временно  Енергийната карта на Западните Балкани придобива нови очертания с подкрепата на САЩ
Енергийната карта на Западните Балкани придобива нови очертания с подкрепата на САЩ 
 ВАС окончателно отмени дерогацията на ТЕЦ "Марица Изток 2"
ВАС окончателно отмени дерогацията на ТЕЦ "Марица Изток 2"  Обедна емисия
Обедна емисия  Нидал Алгафари: Къде бяха кметове и началници, когато се лееше омразата към Дара?
Нидал Алгафари: Къде бяха кметове и началници, когато се лееше омразата към Дара?  Над 1000 деца и родители превърнаха Day Off: Family Time в празник на семейното време
Над 1000 деца и родители превърнаха Day Off: Family Time в празник на семейното време  "Искаме мир": Оръжия по улиците, стрелба на живо в ефир - в Иран мечтаят за край на войната
"Искаме мир": Оръжия по улиците, стрелба на живо в ефир - в Иран мечтаят за край на войната  Почина майката на Десислава Иванчева
Почина майката на Десислава Иванчева 
 ЦСКА има стока, но няма колектив
ЦСКА има стока, но няма колектив  Реал Мадрид с първо лятно попълнение
Реал Мадрид с първо лятно попълнение  Кристина Ич
Кристина Ич  ЦСКА изригна мощно преди финала
ЦСКА изригна мощно преди финала  От Мерцедес: Кими създава голяма еуфория в Италия и това може да е проблем
От Мерцедес: Кими създава голяма еуфория в Италия и това може да е проблем  Проклятие в MotoGP? Още един тежък инцидент, този път със световен шампион
Проклятие в MotoGP? Още един тежък инцидент, този път със световен шампион 
 Защо лилавеят и синеят листата на доматите?
Защо лилавеят и синеят листата на доматите?  Над 1000 деца и родители посетиха Day Off: Family Time
Над 1000 деца и родители посетиха Day Off: Family Time  Италианска торта Barozzi с ядки и шоколад
Италианска торта Barozzi с ядки и шоколад  Пандишпанен кекс без захар
Пандишпанен кекс без захар  Марс преминава в Телец: от 19 май до 28 юни 6 зодии ще има за какво да са доволни
Марс преминава в Телец: от 19 май до 28 юни 6 зодии ще има за какво да са доволни  Неврологът акад. Лъчезар Трайков: Няма по-голям враг за мозъка от скролването
Неврологът акад. Лъчезар Трайков: Няма по-голям враг за мозъка от скролването 
 продава, Едностаен апартамент, 44 m2 Бургас област, с.Равда, 73000 EUR
продава, Едностаен апартамент, 44 m2 Бургас област, с.Равда, 73000 EUR  продава, Къща, 90 m2 Габрово област, с.Крамолин, 36400 EUR
продава, Къща, 90 m2 Габрово област, с.Крамолин, 36400 EUR  продава, Къща, 136 m2 Велико Търново област, с.Петко Каравелово, 100000 EUR
продава, Къща, 136 m2 Велико Търново област, с.Петко Каравелово, 100000 EUR  продава, Къща, 102 m2 Велико Търново област, гр.Дебелец, 175000 EUR
продава, Къща, 102 m2 Велико Търново област, гр.Дебелец, 175000 EUR  продава, Къща, 160 m2 Велико Търново област, гр.Стражица, 159990 EUR
продава, Къща, 160 m2 Велико Търново област, гр.Стражица, 159990 EUR  продава, Къща, 92 m2 Велико Търново област, гр.Златарица, 35000 EUR
продава, Къща, 92 m2 Велико Търново област, гр.Златарица, 35000 EUR 
 Спартак продължава борбата за оцеляване в Първа лига
Спартак продължава борбата за оцеляване в Първа лига  Близо 4000 зрелостници се явят на матура по БЕЛ във Варненско
Близо 4000 зрелостници се явят на матура по БЕЛ във Варненско  Варна отбелязва Европейската нощ на музеите и галериите с безплатен достъп
Варна отбелязва Европейската нощ на музеите и галериите с безплатен достъп  Варна отбелязва 125 години организирано туристическо движение в града
Варна отбелязва 125 години организирано туристическо движение в града  Областният управител Марио Смърков се срещна с мюфтията на Варна
Областният управител Марио Смърков се срещна с мюфтията на Варна  Руски удари в Украйна: Поне един човек е загинал, ранените са над 30
Руски удари в Украйна: Поне един човек е загинал, ранените са над 30 
 Мисии на НАСА изследват рекордно слънчево изригване
Мисии на НАСА изследват рекордно слънчево изригване  Откриха нов вид праисторическа коала в Западна Австралия
Откриха нов вид праисторическа коала в Западна Австралия  Радиоактивен „поздрав“ от свръхнови е открит във вечните ледове на Антарктида
Радиоактивен „поздрав“ от свръхнови е открит във вечните ледове на Антарктида  Уникално откритие: Може да помогне на хората да живеят до 200 години без рак
Уникално откритие: Може да помогне на хората да живеят до 200 години без рак  Десетгодишно търсене на извънземни сигнали сред 70 000 звезди завърши без резултат
Десетгодишно търсене на извънземни сигнали сред 70 000 звезди завърши без резултат  Има ли нещо сензационно в новите файлове за НЛО?
Има ли нещо сензационно в новите файлове за НЛО? 












